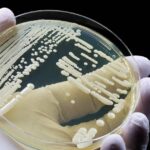
レス1番のリンク先のサムネイル画像

- 1 : 2025/10/27 11:30:07 ???
-
過去のコラム「蚊に刺されれば命を落とす--流行地域が拡大する、恐ろしい感染症」で紹介したように、アジアや中南米、アフリカのみならず欧州でもデング熱の報告が増え、またウエストナイル熱の流行が広がっています。また、ドイツ、オーストリア、北欧などで森などの自然に触れるときにはダニ媒介脳炎という厄介な感染症の対策をしなければなりません。過去のコラム「日本で新種発見 特徴的な症状に乏しいブルセラ」(※1)で紹介した地中海に存在する通称「マルタ熱」と呼ばれるブルセラ症は牛、ヤギ、ヒツジなどの家畜から感染します。また、過去のコラム「国外と北海道で気をつけたい『ダニによる感染症』」(※2)で取り上げたクリミア・コンゴ出血熱もこういった家畜から感染します。そして最近、欧州で新たな感染症が流行し大勢の命を奪っています。その感染症が最初に報告されたのは他ならぬ日本です。今回はこの新しい感染症「カンジドザイマ・アウリス(Candidozyma auris)」を取り上げます。
続きはこちら
https://medical.mainichi.jp/articles/20251024/mmd/00m/411/013000c - 4 : 2025/10/27 11:34:44 S2LXv
- 中国に広めろ。
- 28 : 2025/10/27 12:44:16 Plwri
- >>4
むしろやつらが持ち込んだもの - 5 : 2025/10/27 11:38:20 RwtRm
- ジャップはヘンタイ
世界に迷惑をかけるだけの害虫 - 32 : 2025/10/27 12:50:10 UXJAw
- >>5
食糞文化の朝鮮には隠された病気があるはずニダ - 8 : 2025/10/27 11:46:47 SE8ee
- 毛唐は感染症耐性がアジア人より弱いんやろな
- 9 : 2025/10/27 11:48:28 iSLN0
- たまたま最初に日本で発見されただけで
またあの国ちゃうの?と思ってしまう - 10 : 2025/10/27 11:48:56 Dnzs7
- 日本のビッチどもがご迷惑をかけております
- 11 : 2025/10/27 11:50:17 8ZL5M
- 実に誇らしい
- 12 : 2025/10/27 11:52:50 EGJjM
- これから日本で感染拡大するんだろうな
- 13 : 2025/10/27 11:53:31 zPjrL
- 立ちんぼと生でしたらちんカスが一生出るちんぽになった。
これあかんやつやと思いながらそれ以外の症状出たら病院行こうと思ってて少ししたらおさまった。で別の子と生したらちんぽから膿出てくるようになり諦めて医者行ったら、カンジダ、淋病、クラミジア、梅毒全部陽性やったわwww
新大久保怖すぎてあれ以来ちゃんとした店にしてる - 16 : 2025/10/27 12:02:00 qmw12
- >>13
エイズは? - 17 : 2025/10/27 12:11:56 NsB0k
- かーい
かいかい
かーい
かいかい
ゆかい
つーかい - 18 : 2025/10/27 12:14:22 3LjSc
- >>17
もう始まったザンス! - 30 : 2025/10/27 12:48:24 PA7Jv
- >>17
あーちちあーち カンジダだろうか - 19 : 2025/10/27 12:17:04 MX1uI
- 鎖国の時は梅毒しか流行らなかったのに
もう終わりだよこの国 - 20 : 2025/10/27 12:22:16 pepeu
- 日本で発見😭
- 21 : 2025/10/27 12:25:44 BriQB
- 性病の見本市みたいな国になりつつあるな。
- 22 : 2025/10/27 12:26:59 FIM1W
- 手コキ店で様子をみるか
- 23 : 2025/10/27 12:28:24 hH0SU
- カンジドザイタマ・アウリス
埼玉発祥か - 24 : 2025/10/27 12:28:45 LZEMJ
- 日本の女は性病ばっかアルヨ
- 25 : 2025/10/27 12:30:01 1OeSq
- いたづらに怖がらず話しかけてみよう?好
- 27 : 2025/10/27 12:41:06 p4wIq
- ヘルペスとか一回身体にはいると一生残るんでしょ?
怖い - 29 : 2025/10/27 12:46:49 WH4Nu
- 風俗店
中国人だらけだよ - 31 : 2025/10/27 12:49:14 6Sq5o
- 世界中から人が流入しすぎている。
日本は感染症爆心地となった。 - 33 : 2025/10/27 12:50:48 9XHjv
- 人から人に感染しないからコロナよりマシだ
- 34 : 2025/10/27 12:51:00 jj5Ct
- 売春大国だからな
- 35 : 2025/10/27 12:52:24 XhO5a
- 中国由来だろ
警戒しないと
- 36 : 2025/10/27 13:02:14 P1h5W
- 風俗
マッチングアプリ
やらないことだわ - 37 : 2025/10/27 13:02:44 YKzQr
- ブルセラで感じた症?
【性病】日本で発見の新種カンジダ 薬が効かず欧米で感染拡大
talkニュー速+

コメント